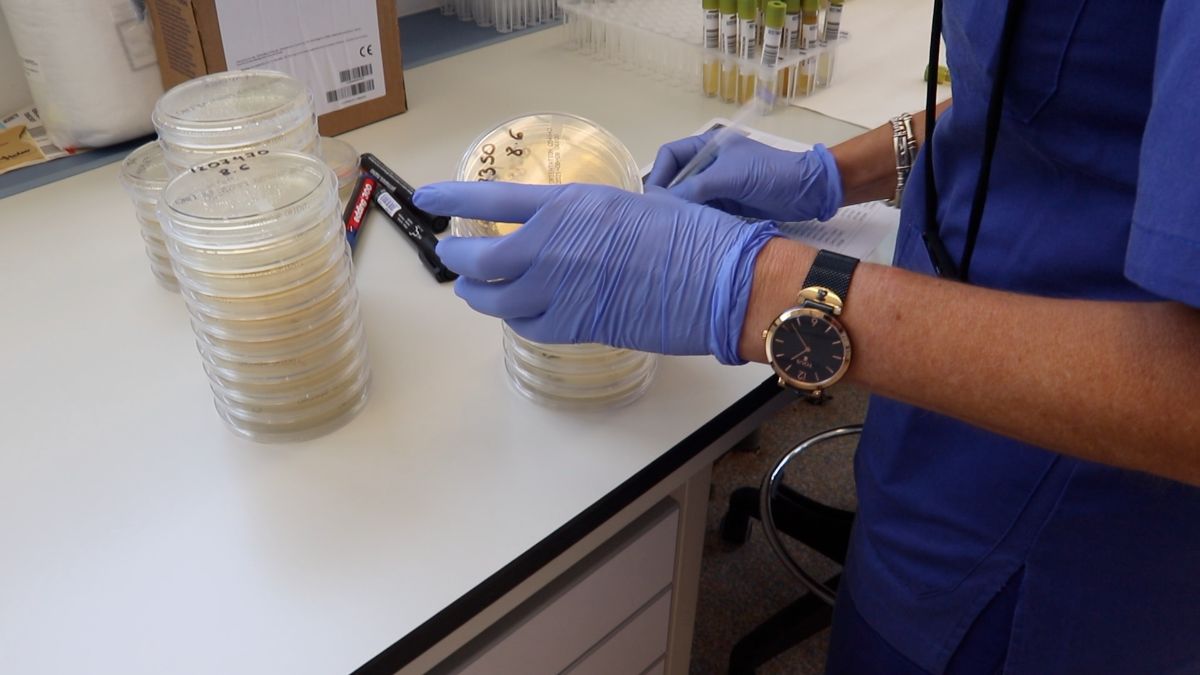
micro-analisis-clínico

El Instituto Nacional de Gestión Sanitaria (INGESA) ha adquirido, para el laboratorio de Análisis Clínico del Hospital Universitario de Ceuta, dos nuevos autoanalizadores de última tecnología que servirán para mejorar la capacidad diagnóstica de la COVID-19 frente a las variantes de la COVID-19 que permitirán ofrecer una mejor calidad asistencial a los pacientes.
En esta línea, INGESA sigue poniendo en marcha medidas extraordinarias con el objetivo de controlar la pandemia en Ceuta y que, ante posibles olas futuras, haya una afectación mínima. La incorporación de estos dos equipos resulta esencial y significa un nuevo salto en la lucha contra el virus.
Para la doctora y jefe del Laboratorio de Análisis Clínico, Marisol Martínez, esta adquisición es “fundamental”, ya que “se va a aumentar la sensibilidad diagnóstica, tendremos menos falsos negativos y podremos aumentar la capacidad diagnóstica al realizar un mayor número de pruebas”
De los dos nuevos autoanalizadores, uno de ellos es un extractor totalmente automatizado de ácido nucleico que permite realizar la extracción de la ARN del virus, y el otro es un termociclador que permite identificar, a tiempo real, el genoma del virus utilizando hasta cuatro dianas génicas diferentes.
“Nosotros disponíamos de esta tecnología frente a la COVID-19, pero con la aparición de nuevas variantes como puede ser la variante británica o la sudafricana, se pone de manifiesto que el virus está mutando, por lo que nuestra capacidad diagnóstica se podía ver limitada y con la llegada de esta nueva PCR podemos aumentar nuestra sensibilidad diagnóstica”
La llegada de estos equipos permite realizar hasta 94 PCR en una sola tanda
El Instituto Nacional de Gestión Sanitaria ha adquirido dos autoanalizadores nuevos fundamentalmente para llevar a cabo la PCR del coronavirus y la facultativa, especialista en Bioquímica Clínica, Salomé Hijano Villegas, ha detallado que una de ellas es un Starlet que “permite la extracción del RNA, la purificación de este y la preparación del Master Mix, que son las herramientas que vamos a utilizar para llevar a cabo la reacción en cadena de la polimerasa”.
El Instituto Nacional de Gestión Sanitaria ha adquirido dos autoanalizadores nuevos fundamentalmente para llevar a cabo la PCR del coronavirus y la facultativa, especialista en Bioquímica Clínica, Salomé Hijano Villegas, ha detallado que una de ellas es un Starlet que “permite la extracción del RNA, la purificación de este y la preparación del Master Mix, que son las herramientas que vamos a utilizar para llevar a cabo la reacción en cadena de la polimerasa”.
Otra de las ventajas de estos nuevos equipos es que se va a aumentar considerablemente la capacidad diagnóstica, ya que se pueden realizar hasta 94 PCR en una sola tanda. “Es una PCR robusta y sensible que utiliza cuatro sondas génicas que van a hibridar en cuatro regiones del RNA por lo que tendremos una bajísima cantidad de falsos negativos”, apunta Hijano, quien recuerda que la incorporación de estos equipos es la última tecnología en relación con el diagnóstico del coronavirus y en el futuro también podrá aplicarse para diagnosticar otro tipo de patologías en el futuro”.
Esta tecnología permitirá mejorar en el diagnóstico de muchas otras patologías en el futuro
La facultativa especialista en Microbiología y Parasitología, Patricia González Donapetry, destaca que la llegada de estas máquinas no solo supone un gran salto para la detección del SARS-COV2, sino que también existe un campo mucho más amplio “que debe ser tenido en cuenta, y que permitirá mejorar el diagnóstico de otras muchas patologías en el futuro como por ejemplo el Virus del Papiloma Humano, que es muy importante para la detección precoz del cáncer cervical”.
sino que también existe un campo mucho más amplio “que debe ser tenido en cuenta, y que permitirá mejorar el diagnóstico de otras muchas patologías en el futuro como por ejemplo el Virus del Papiloma Humano, que es muy importante para la detección precoz del cáncer cervical”.
Por último, la facultativa asegura que estos equipos también podrán tener aplicaciones en la mejora del diagnóstico de las patologías digestivas y en enfermedades de transmisión sexual.






